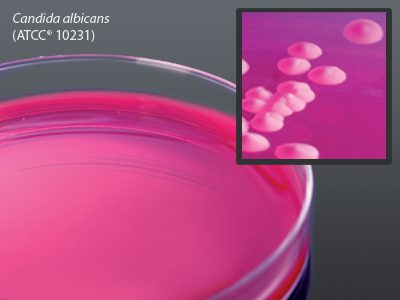

Bioreagents
Tryptic Soy Broth (TSB), Hardy Diagnostics – K285, 2 mL, Filtered
$39.61MEDIUM TRYPTIC SOY BROTH 2ML/16X100MM
Dichloran Rose Bengal Chloramphenicol Agar, Hardy Diagnostics – G389, 15 x 100 mm
$28.93MEDIUM DRBC AGAR 5X100MM PLATE/18ML FILL
LabRobot Dilushaker III Digital, Hardy Diagnostics – 40DEBPW6, 6 Rows, 16 Trays, 7×6 Cups, Dilucup Elegance BPW
$674.74DILUCUP ELEGANCE BPW W/16 7X6 TRAY 9ML
LabRobot Dilushaker III Digital, Hardy Diagnostics – 40DEMRD6, 6 Rows, 16 Trays, 7×6 Cups, Dilucup Elegance MRD
$663.16DILUCUP ELEGANCE MRD W/16 7X6 TRAY 9ML
Accessories for LabRobot Dilushaker III Digital, Hardy Diagnostics – 40SC07, Special Scissors for separating the DiluCups
$51.51SCISSOR SPECIAL DILUCUPS FOR DILUSHAKER
Accessories for LabRobot Dilushaker III Digital, Hardy Diagnostics – 40TC1567, Transport Suitcase for 2 Dilushakers, with 2 Wheels and Trolley Handle
$884.88SUITCASE TRANSPORT F/DILUSHAKERS W/WHEEL
Accessories for LabRobot Dilushaker III Digital, Hardy Diagnostics – 40PS12, Power Supply 12V for Dilushaker
$110.31POWER SUPPLY 12V F/DILUSHAKER II AND III
Accessories for LabRobot Dilushaker III Digital, Hardy Diagnostics – 40FS02, Footswitch for Dilushaker
$174.21FOOTSWITCH F/DILUSHAKER LABROBOT
Accessories for LabRobot Dilushaker III Digital, Hardy Diagnostics – 40ET21XT, Removable Tray for Dilucup, 21 Cups, 3 Rows
$251.59TRAY REMOVABLE W/O ADAP 21CUP F/DILUCUP
LabRobot Dilushaker III Digital, Hardy Diagnostics – 40DS21PRXT, Dilushaker III Digital; 3 Rows, LED, 21 Cups, 7×3
$2,872.79DILUSHAKER III DIG 3 ROW LED INDCR 21CUP
Blood Agar, Hardy Diagnostics – J93, Blood Agar/Blood Agar Biplate
$28.91MEDIUM BIPLATE BLOOD AGAR 5% CULTIVATION